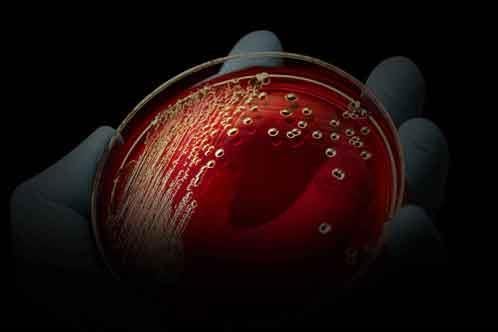

A RESISTÊNCIA AOS ANTIBIÓTICOS
O que significa a resistência aos antibióticos? Como se desenvolve essa resistência? Quais são as consequências para as nossas vidas? Queremos esclarecer tudo isso com esta nossa iniciativa. Porque apenas entendendo as causas e as consequências da resistência aos antibióticos é que poderá agir com responsabilidade ao utilizar antibióticos.
BACTÉRIAS E VÍRUS
Bactérias e vírus são completamente diferentes. Uma descoberta importante, porque os antibióticos são ineficazes contra vírus

DE QUE FORMA SÃO DESENVOLVIDAS AS RESISTÊNCIAS?
Quando as bactérias se tornam imunes aos antibióticos, falamos de resistência. Mas de que forma é que isso acontece?

DE QUE FORMA FUNCIONAM OS ANTIBIÓTICOS?
Antibióticos, modo de ação de uma suposta cura milagrosa.
AS CONSEQUÊNCIAS.
Uma pequena lesão com consequências fatais? As consequências da resistência aos antibióticos podem ser devastadoras.
.jpg?width=360&height=360&format=jpg&quality=80)
AS CAUSAS.
Uso muito frequente de antibióticos e outras causas que agora estão a ser observadas.
.jpg?width=504&height=410&format=jpg&quality=80)
CONTACTOS
Contactos e perguntas da imprensa sobre a iniciativa "A responsabilidade é o melhor remédio".

PERGUNTAS FREQUENTES
Perguntas frequentes sobre resistência a antibióticos e a iniciativa "A responsabilidade é o melhor remédio".

